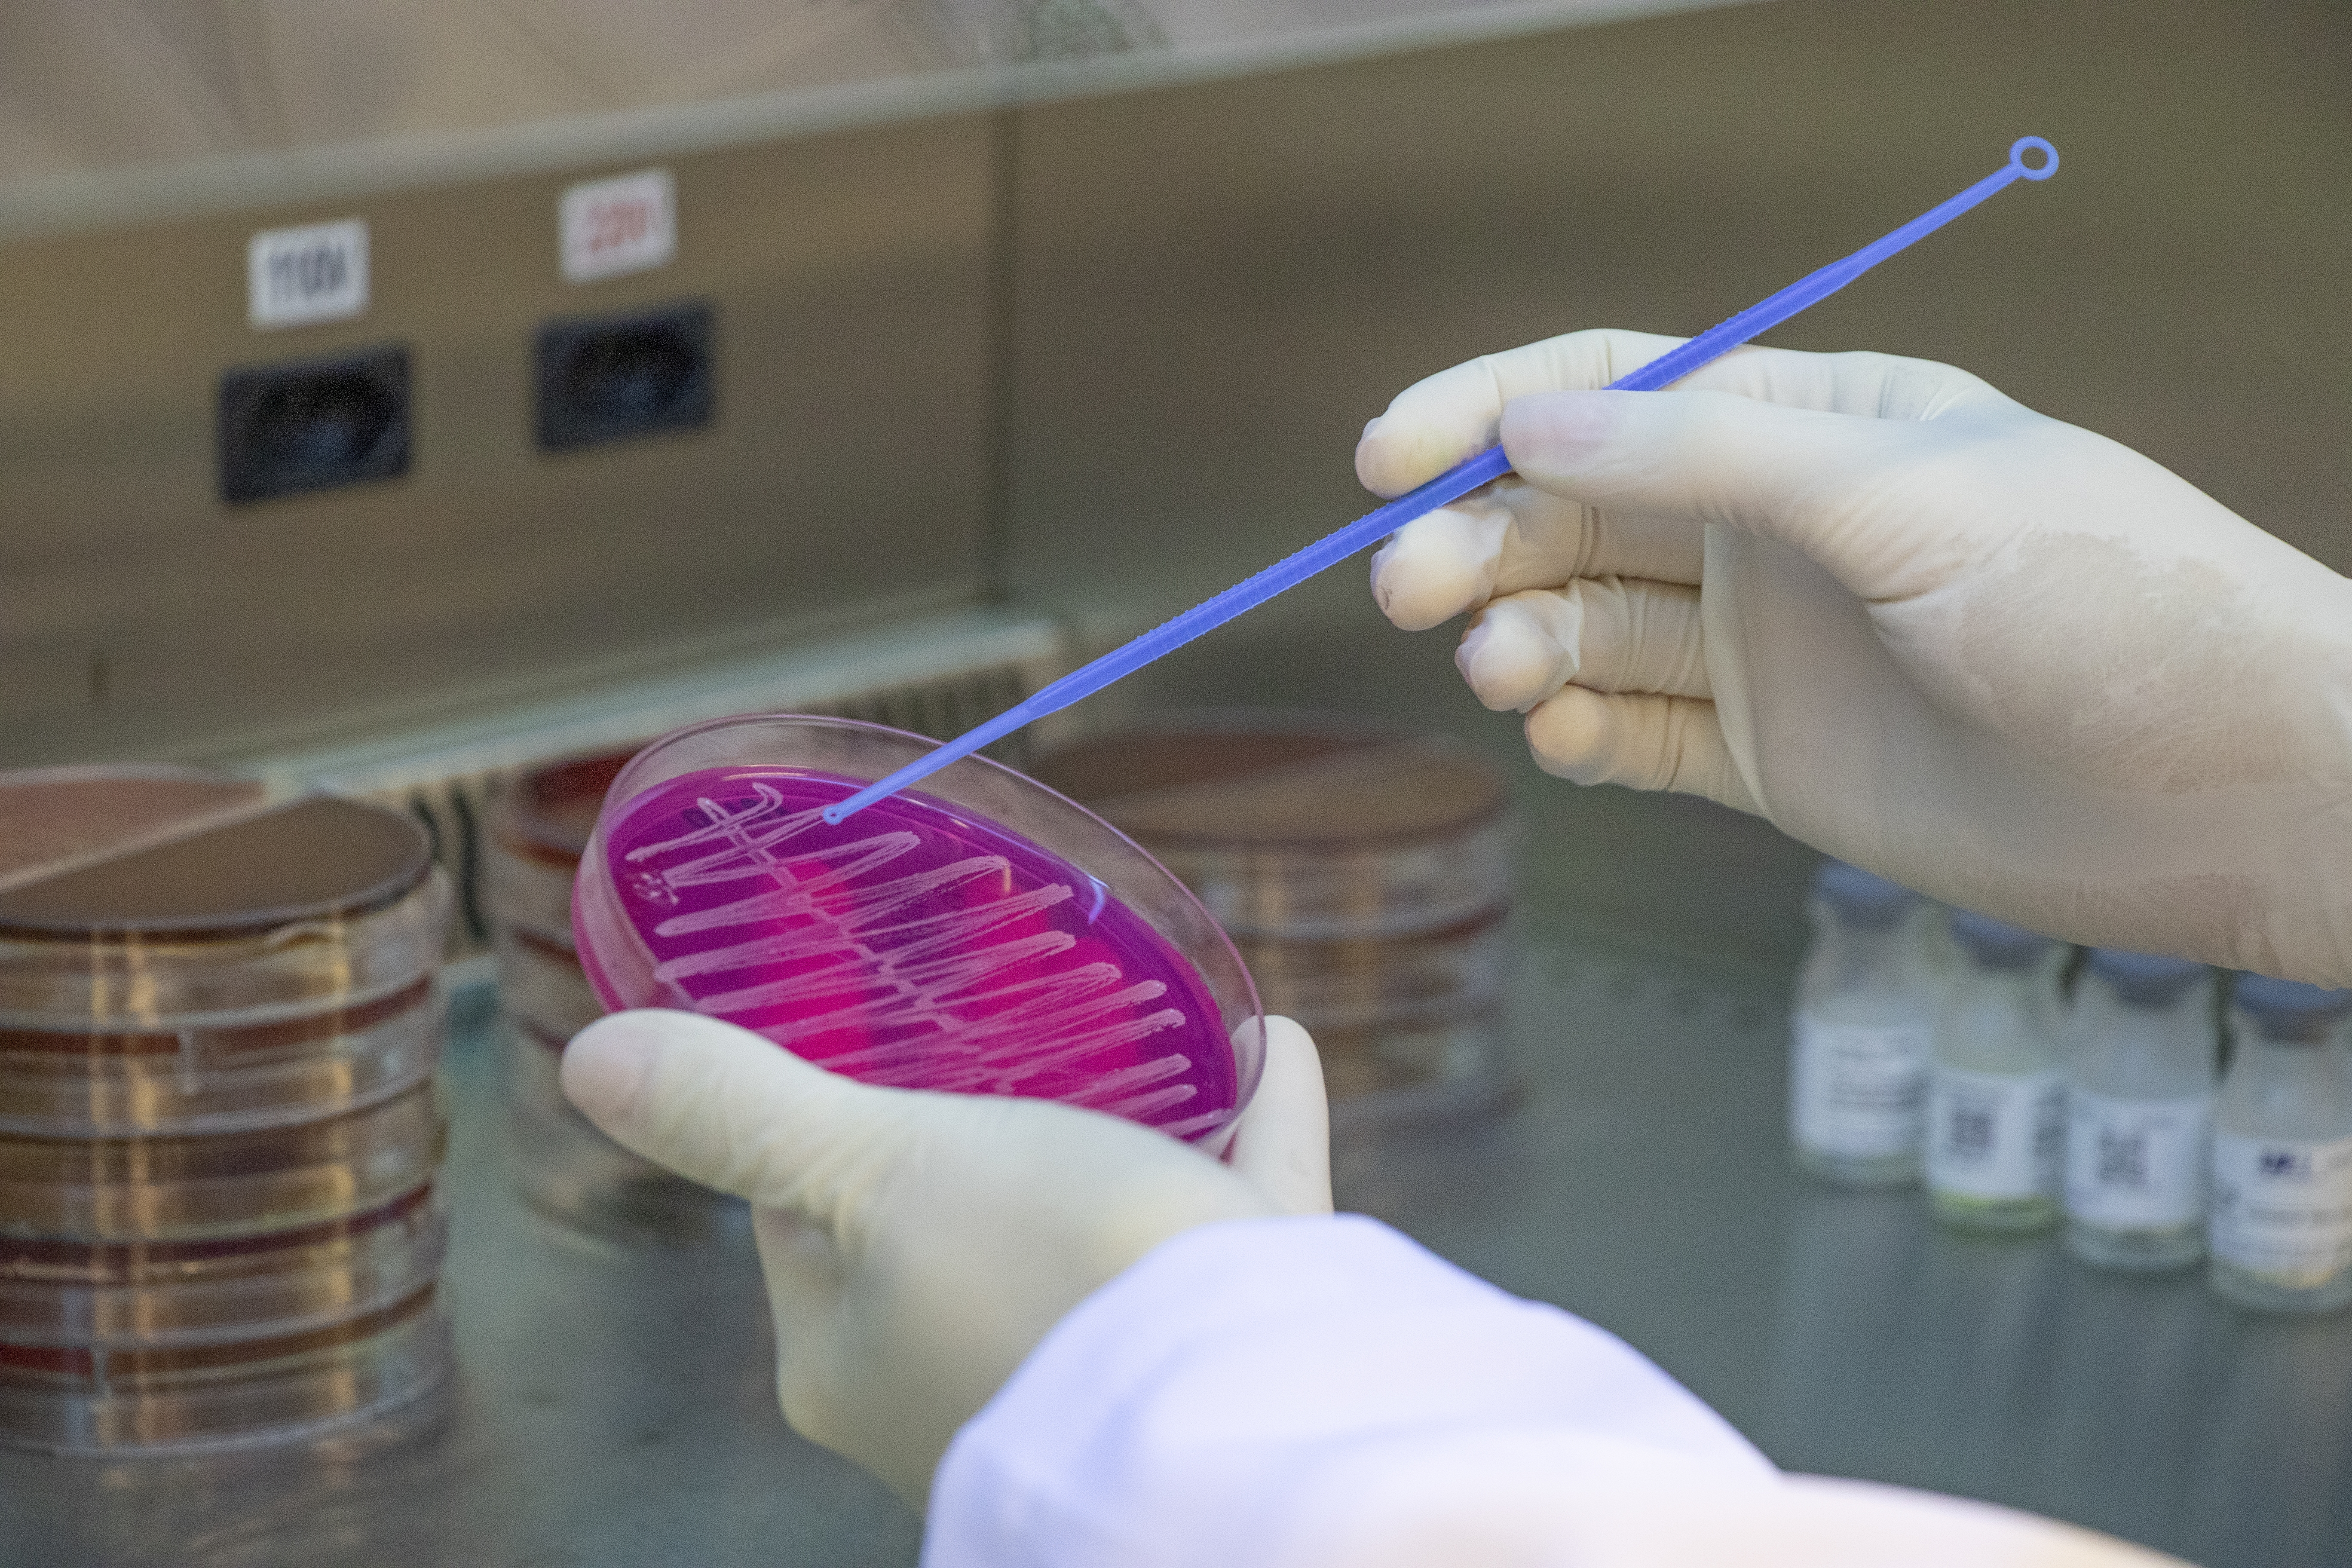

Já quis descobrir ? o que você vai estudar no curso de Biomedicina? Pode ser que as informações que reunimos no post de hoje o ajudem a entender melhor como funciona a faculdade que forma profissionais que atuam na área de diagnóstico. Fique de olho ? em nossa matéria:
Durante a leitura do texto O que vou estudar no curso de Biomedicina?, preste atenção nas letras sublinhadas no início de alguns parágrafos. Ao final da matéria, reunindo todas elas, você descobrirá o apelido da biomédica brasileira que foi reconhecida mundialmente por ter desenvolvido um trabalho de pesquisa importantíssimo na área da saúde. #girlpower #vaiBrasil
A profissão ?
Como o curso de Biomedicina está organizado? ?
Quando ingressam no curso de Biomedicina, os estudantes logo ouvem falar da grade curricular da graduação, composta de disciplinas teóricas e práticas. A faculdade tem duração média de 4 anos e, no decorrer de oito semestres, você vai estudar matérias como Anatomia e Fisiologia Humana, Biofísica, Bioquímica Geral, Estética Biomédica e Análises Toxicológicas. Conheça detalhes de duas dessas disciplinas:
? Anatomia e Fisiologia Humana: nesta matéria você vai estudar as características dos diversos sistemas do corpo humano e o modo como eles funcionam em conjunto;
? Análises Toxicológicas: matriculado nesta disciplina, você vai estudar os principais agentes causadores de intoxicações humanas e procedimentos forenses (imaginamos que tenha lembrado do trabalho que os personagens de CSI* realizam na série de TV, não é? De fato, existem semelhanças entre as atividades profissionais da área biomédica desempenhadas na vida real e na ficção).
Estágios na área biomédica ?
Uhu, veja só que bacana: durante a graduação, os alunos do curso de Biomedicina podem realizar estágios profissionais no seu ramo de formação para ganhar uma graninha extra, enriquecer o currículo e acumular experiências que certamente irão diferenciá-los no mercado de trabalho formal. ??
Estagiários da área biomédica devem sempre exercer funções profissionais sob a supervisão de colegas diplomados e atuantes no ramo. Os aprendizes podem, por exemplo, auxiliar na checagem de exames, acompanhar pacientes em alguns procedimentos médicos e atuar em laboratórios de análises clínicas, realizando atividades nos setores de triagem de amostra, bioquímica, hematologia e coagulação, endocrinologia e sorologia.
Trabalhe como a Jaque! ???
Quem vem acompanhando os noticiários nos últimos tempos deve ter se familiarizado com os nomes das CIENTISTAS BRASILEIRAS que em apenas 48 horas conseguiram sequenciar o genoma do coronavírus (cientificamente denominado SARS-CoV-2). Vale mencionar que uma das pesquisadoras envolvidas no estudo atua (olha só!) como BIOMÉDICA! ?
Jaqueline Goes de Jesus (a Jaque, como decidimos chamá-la nesta matéria) frequentou o curso de Biomedicina da Escola Bahiana de Medicina e Saúde Pública e seguiu estudando até tornar-se pós-doutoranda na Faculdade de Medicina da Universidade de São Paulo (FMUSP). Atualmente é bolsista da Fundação de Amparo à Pesquisa do Estado de São Paulo (Fapesp) e trabalha desenvolvendo pesquisas na área de arboviroses emergentes. Também integra o ZIBRA Project (Zika in Brazil Real Time Analysis), um projeto itinerante de mapeamento genômico do vírus Zika no Brasil.
E aí, ficou impressionado com as atividades profissionais que a Jaque desenvolve? Sabia que, no futuro, você também pode exercer as mesmas funções que ela? Para isso, não perca mais tempo e ingresse já no curso de Biomedicina! ?
*CSI: Crime Scene Investigation é uma série de televisão norte-americana centrada nas investigações de um grupo de cientistas forenses do departamento de criminalística da polícia de Las Vegas, em Nevada.
Curte a área da saúde, mas ainda não sabe qual profissão do ramo seguir? Fique de olho em nossas sugestões:
? Em quais áreas um dentista pode trabalhar?
? O que vou estudar no curso de Enfermagem?
? Como funciona o mercado de trabalho para farmacêuticos?
? Dez motivos para você fazer Medicina em nossa Universidade